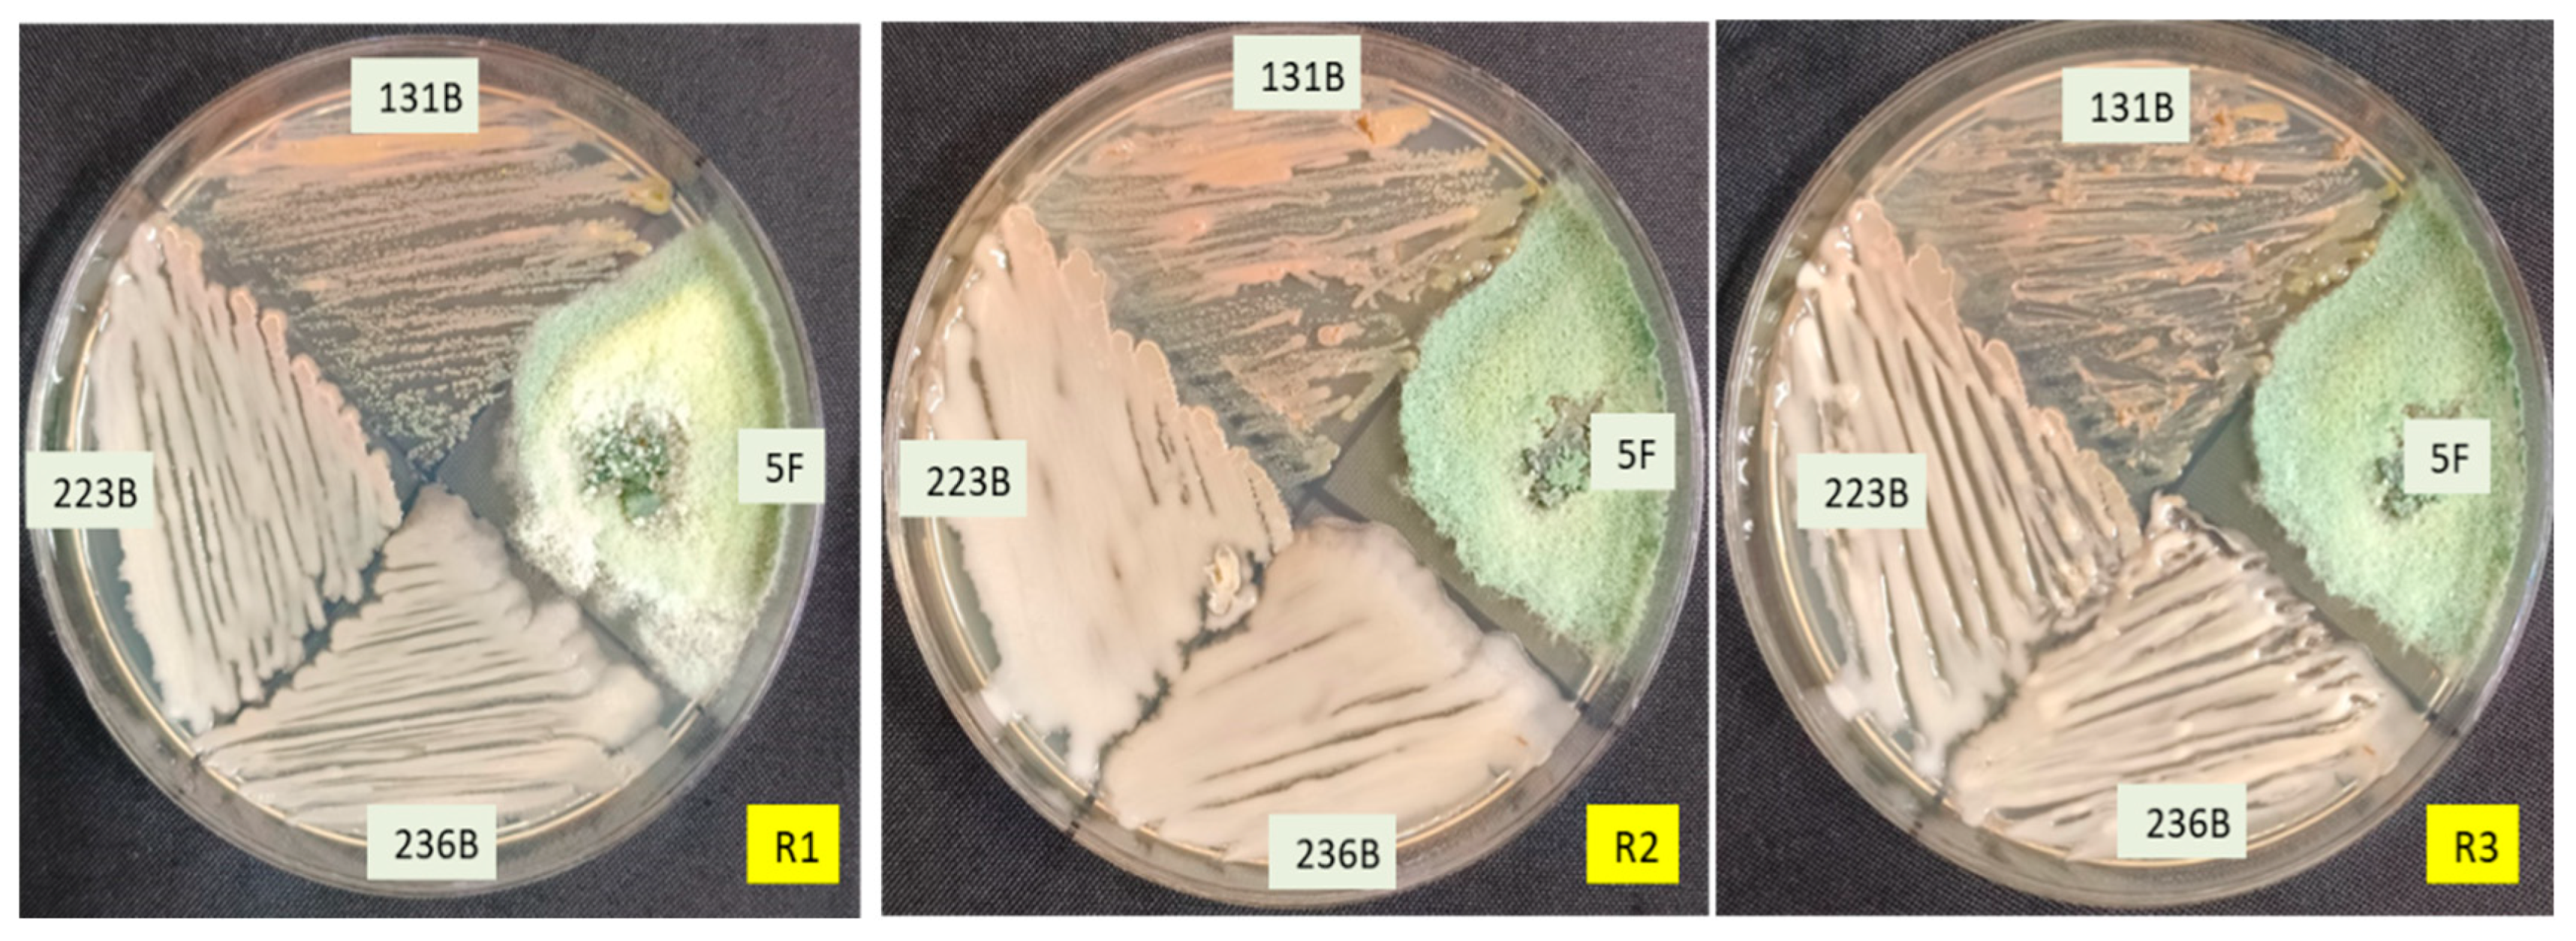
Microorganisms 12 02331 g006

Isolation and Characterization of Biocontrol Microbes for Development of Effective Microbial Consortia for Managing Rhizoctonia bataticola Root Rot of Cluster Bean Under Hot Arid Climatic Conditions
Abstract
1. Introduction
2. Materials and Methods
2.1. Isolation of Rhizospheric and Endophytic Microbes Form Plant and Soil Samples
2.2. Dual Plate Assay of Isolated Microbes for Antagonistic Activity Against Rhizoctonia bataticola
2.3. Assessment of Selected Microbial Isolates for Abiotic Stress Tolerance
2.4. Characterization of Selected Microbial Isolates for Their Biocontrol and Plant Growth-Promoting Properties
2.5. Assessment of Compatibility Among Selected Biocontrol Agents
2.6. Morphological, Physiological and Biochemical Characterization of Selected Biocontrol Agents
2.7. Molecular Identification of Selected Isolates Using 16S rRNA and ITS Gene Sequencing
2.8. Pot Experiment
2.8.1. Percent Disease Incidence
2.8.2. Estimation of Total Phenol and Flavonoid
2.8.3. Quantitative Determination of Antioxidant-Defense Enzymes
2.8.4. Measurement of Plant Height, Biomass, Yield and Yield Attributes
2.9. Statistical Analysis
3. Results
3.1. Dual Plate Assay of Isolated Microbes for Antagonistic Activity Against Rhizoctonia bataticola
3.2. Assessment of Selected Fungal Isolates for Abiotic Stress Tolerance
3.3. Assessment of Selected Bacterial Isolates for Abiotic Stress Tolerance
3.4. Characterization of Selected Microbial Isolates for Their Biocontrol and Plant Growth-Promoting Properties
3.5. Assessment of Compatibility Among Selected Biocontrol Agents
3.6. Morphological, Physiological and Biochemical Characterization of Selected Biocontrol Agents
3.7. Molecular Identification of Selected Isolates Using 16S rRNA and ITS Gene Sequencing
3.8. Bioefficacy Evaluation of Selected Biocontrol Agents Against Rhizoctonia bataticola
3.9. Impact of Individual and Consortium Applications of Biocontrol Agents on Biochemical Characteristics and Antioxidant Defense Enzymes in Cluster Bean Against Rhizoctonia bataticola
3.10. Impact of Biocontrol Agents on Growth, Biomass, Yield, and Yield Attributes of Cluster Bean Plants Challenged with Rhizoctonia bataticola
4. Discussion
5. Conclusions
Supplementary Materials
Author Contributions
Funding
Data Availability Statement
Acknowledgments
Conflicts of Interest
References
- Mahla, H.R.; Rani, R.; Choudhary, K.B.; Rajput, L.S.; Sharma, R. Genomics-Aided Breeding Strategies for Biotic Stress in Cluster Bean. In Genomics-Aided Breeding Strategies for Biotic Stress in Grain Legumes; Parihar, A.K., Bohra, A., Lamichaney, A., Mishra, R., Varshney, R.K., Eds.; Springer: Singapore, 2024; pp. 495–518. [Google Scholar] [CrossRef]
- Madni, A.; Khalid, A.; Wahid, F.; Ayub, H.; Khan, R.; Kousar, R. Preparation and applications of guar gum composites in biomedical, pharmaceutical, food, and cosmetics industries. Curr. Nanosci. 2021, 17, 365–379. [Google Scholar] [CrossRef]
- Saxena, D.R.; Kumbhkar, R.; Saxena, M.; Tiwari, N.; Kumar, T.; Chauhan, A. Morpho-pathogenic and molecular diversity among Rhizoctonia bataticola isolates causing dry root rot of chickpea in Madhya Pradesh, India. J. Environ. Biol. 2022, 43, 852–863. [Google Scholar] [CrossRef]
- Sangeetha, T.V.; Jahagirdar, S. Screening fungicides against Sclerotium rolfsii, Rhizoctonia bataicola and Fusarium sp. causing root rot/wilt of soybean. Bioinfolet 2013, 10, 38–41. [Google Scholar]
- Qu, C.; Albanese, S.; Lima, A.; Hope, D.; Pond, P.; Fortelli, A.; Romano, N.; Cerino, P.; Pizzolante, A.; De Vivo, B. The occurrence of OCPs, PCBs, and PAHs in the soil, air, and bulk deposition of the Naples metropolitan area, southern Italy: Implications for sources and environmental processes. Environ. Int. 2019, 124, 89–97. [Google Scholar] [CrossRef] [PubMed]
- Sharma, A.; Kumar, V.; Shahzad, B.; Tanveer, M.; Sidhu, G.P.S.; Handa, N.; Kohli, S.K.; Yadav, P.; Bali, A.S.; Parihar, R.D.; et al. Worldwide pesticide usage and its impacts on ecosystem. SN Appl. Sci. 2019, 1, 1446. [Google Scholar] [CrossRef]
- Meena, R.S.; Kumar, S.; Datta, R.; Lal, R.; Vijayakumar, V.; Brtnicky, M.; Sharma, M.P.; Yadav, G.S.; Jhariya, M.K.; Jangir, C.K.; et al. Impact of agrochemicals on soil microbiota and management: A review. Land 2020, 9, 34. [Google Scholar] [CrossRef]
- Beaumelle, L.; Tison, L.; Eisenhauer, N.; Hines, J.; Malladi, S.; Pelosi, C.; Thouvenot, L.; Phillips, H.R. Pesticide effects on soil fauna communities—A meta-analysis. J. Appl. Ecol. 2023, 60, 1239–1253. [Google Scholar] [CrossRef]
- De Curtis, F.; De Felice, D.V.; Ianiri, G.; De Cicco, V.; Castoria, R. Environmental factors affect the activity of biocontrol agents against ochratoxigenic Aspergillus carbonarius on wine grape. Int. J. Food Microbiol. 2012, 159, 17–24. [Google Scholar] [CrossRef]
- Pertot, I.; Angeli, D.; Agra, O.; Elad, Y. Effect of temperature on microbial biocontrol agents of plant diseases. IOBC/WPRS Bull. 2012, 78, 23. [Google Scholar]
- Vinale, F.; Ghisalberti, E.L.; Sivasithamparam, K.; Marra, R.; Ritieni, A.; Ferracane, R.; Woo, S.; Lorito, M. Factors affecting the production of Trichoderma harzianum secondary metabolites during the interaction with different plant pathogens. J. Appl. Microbiol. 2009, 48, 705–711. [Google Scholar]
- Maciag, T.; Kozieł, E.; Rusin, P.; Otulak-Kozieł, K.; Jafra, S.; Czajkowski, R. Microbial consortia for plant protection against diseases: More than the sum of its parts. Int. J. Mol. Sci. 2023, 24, 12227. [Google Scholar] [CrossRef] [PubMed]
- Nunes, P.S.; Junior, G.V.L.; Mascarin, G.M.; Guimarães, R.A.; Medeiros, F.H.; Arthurs, S.; Bettiol, W. Microbial consortium of biological products: Do they have a future? Biol. Control. 2024, 188, 105439. [Google Scholar] [CrossRef]
- Dinis, M.; Vicente, J.R.; César de Sá, N.; López-Núñez, F.A.; Marchante, E.; Marchante, H. Can Niche Dynamics and Distribution Modeling Predict the Success of Invasive Species Management Using Biocontrol? Insights from Acacia longifolia in Portugal. Front. Ecol. Evol. 2020, 8, 576667. [Google Scholar] [CrossRef]
- Kozieł, E.; Bujarski, J.J.; Otulak-Kozieł, K. Plant cell apoplast and symplast dynamic association with plant-RNA virus interactions as a vital effect of host response. In Plant RNA Viruses Molecular Pathogenesis and Management, 1st ed.; Gaur, R.K., Patil, B.E., Selvarajan, R., Eds.; Academic Press: London, UK, 2023; Volume 16, pp. 311–328. [Google Scholar]
- Ram, R.M.; Debnath, A.; Negi, S.; Singh, H.B. Use of microbial consortia for broad spectrum protection of plant pathogens. Biopesticides 2021, 2, 319–335. [Google Scholar]
- Minchev, Z.; Kostenko, O.; Soler, R.; Pozo, M.J. Microbial consortia for effective biocontrol of root and foliar diseases in tomato. Front. Plant Sci. 2021, 12, 756368. [Google Scholar] [CrossRef]
- Thakkar, A.; Saraf, M. Development of microbial consortia as a biocontrol agent for effective management of fungal diseases in Glycine max L. Arch. Phytopathol. Plant Prot. 2014, 48, 459–474. [Google Scholar] [CrossRef]
- Gindi, A.; Gopalakrishnan, S.; Naik, M.K. Efficacy of Streptomyces spp. and Bacillus spp. for their antagonistic potential against dry root rot (Rhizoctonia bataticola) of chickpea. Andhra Pradesh J. Agric. Sci. 2018, 4, 149–156. [Google Scholar]
- Senthilkumar, M.; Swarnalakshmi, K.; Govindasamy, V.; Lee, Y.K.; Annapurna, K. Biocontrol potential of soybean bacterial endophytes against charcoal rot fungus, Rhizoctonia bataticola. Curr. Microbiol. 2009, 58, 288–293. [Google Scholar] [CrossRef]
- Khendkar, A.S.; Deshpande, A.R. Isolation, identification and antagonistic potential of Streptomyces ANSCa22 for biocontrol of Rhizoctonia bataticola infection of soybean. Plant Arch. 2020, 20, 701–707. [Google Scholar]
- Rudolph, N.; Labuschagne, N.; Aveling, T.A.S. The effect of plant growth promoting rhizobacteria on seed germination and seedling growth of maize. Seed Sci. Technol. 2015, 43, 507–518. [Google Scholar] [CrossRef]
- El-Sayed, W.S.; Akhkha, A.; El-Naggar, M.Y.; Elbadry, M. In vitro antagonistic activity, plant growth promoting traits and phylogenetic affiliation of rhizobacteria associated with wild plants grown in arid soil. Front. Microbiol. 2014, 5, 651. [Google Scholar] [CrossRef] [PubMed]
- Poosapati, S.; Ravulapalli, P.D.; Tippirishetty, N.; Vishwanathaswamy, D.K.; Chunduri, S. Selection of high temperature and salinity tolerant Trichoderma isolates with antagonistic activity against Sclerotium rolfsii. SpringerPlus 2014, 3, 641. [Google Scholar] [CrossRef] [PubMed]
- Kumar, G.P.; Ahmed, S.K.M.H.; Desai, S.; Amalraj, E.L.D.; Rasul, A. In Vitro screening for abiotic stress tolerance in potent biocontrol and plant growth promoting strains of Pseudomonas and Bacillus spp. Int. J. Microbiol. 2014, 2024, 195946. [Google Scholar]
- Kumari, T.V.; Basu, K.A.U.S.I.K.; Nithya, T.G.; Varma, A.J.I.T.; Kharkwal, A.C. Isolation and screening of alkali tolerant Trichoderma spp. as biocontrol agent for alkaline agricultural soil. Int. J. Pharm. Pharm. Sci. 2014, 6, 512–516. [Google Scholar]
- Rai, A.; Jha, M.N.; Singh, D.; Thapa, S.; Chaurasia, S.K.; Jha, G. Detection of endophytic association between Aeschynomene nodulating Bradyrhizobium sp. and traditional Desariya rice roots under rice-Aeschynomene ecosystem of chaur land, Bihar, India. Biol. Future 2021, 73, 95–105. [Google Scholar] [CrossRef] [PubMed]
- Zahra, S.T.; Tariq, M.; Abdullah, M.; Zafar, M.; Yasmeen, T.; Shahid, M.S.; Zaki, H.E.; Ali, A. Probing the potential of salinity-tolerant endophytic bacteria to improve the growth of mungbean [Vigna radiata (L.) Wilczek]. Front. Microbiol. 2023, 14, 1149004. [Google Scholar] [CrossRef]
- Sandhya, V.; Ali, S.Z.; Venkatesvarlu, B.; Reddy, G.; Grover, M. Effect of osmotic stress on plant growth promoting Pseudomonas spp. Arch. Microbiol. 2020, 192, 867–876. [Google Scholar] [CrossRef]
- Milagres, A.M.F.; Machuca, A.; Napoleão, D. Detection of siderophore production from several fungi and bacteria by a modification of chrome azurol S (CAS) agar plate assay. J. Microbiol. Methods 1999, 37, 1–6. [Google Scholar] [CrossRef]
- Castric, P.A. Hydrogen cyanide, a secondary metabolite of Pseudomonas aeruginosa. Can. J. Microbiol. 1975, 21, 613–618. [Google Scholar] [CrossRef]
- Dye, D.W. The inadequacy of the usual determinative tests for identification of Xanthomonas sp. N. Z. J. Sci. 1962, 5, 393–416. [Google Scholar]
- Zou, X.; Nonogaki, H.; Welbaum, G.E. A gel diffusion assay for visualization and quantification of chitinase activity. Mol. Biotechnol. 2002, 22, 19–23. [Google Scholar] [CrossRef] [PubMed]
- Zacky, F.A.; Ting, A.S.Y. Investigating the bioactivity of cells and cell-free extracts of Streptomyces griseus towards Fusarium oxysporum f. sp. cubense race 4. Biol. Control. 2013, 66, 204–208. [Google Scholar] [CrossRef]
- Saito, A.; Ooya, T.; Miyatsuchi, D.; Fuchigami, H.; Terakado, K.; Nakayama, S.Y.; Watanabe, T.; Nagata, Y.; Ando, A. Molecular characterization and antifungal activity of a family 46 chitosanase from Amycolatopsis sp. CsO-2. FEMS Microbiol. Lett. 2009, 293, 79–84. [Google Scholar] [CrossRef] [PubMed]
- Lepcha, K.; Ghosh, S. Glycoside hydrolases from a thermophilic microbial consortium and their implication in the saccharification of agroresidues. Biocat. Agric. Biotechnol. 2018, 15, 160–166. [Google Scholar] [CrossRef]
- Muniroh, M.S.; Nusaibah, S.A.; Vadamalai, G.; Siddique, Y. Proficiency of biocontrol agents as plant growth promoters and hydrolytic enzyme producers in Ganoderma boninense infected oil palm seedlings. Curr. Plant Biol. 2019, 20, 100116. [Google Scholar] [CrossRef]
- Pikovskaya, R.I. Mobilization of phosphorous in soil in connection with vital activity of some microbial species. Mikrobiologiya 1948, 17, 362–370. [Google Scholar]
- Fasim, F.; Ahmed, N.; Parsons, R.; Gadd, G.M. Solubilization of zinc salts by a bacterium isolated from the air environment of a tannery. FEMS Microbiol. Lett. 2002, 213, 1–6. [Google Scholar] [CrossRef]
- Patten, C.; Glick, B. Role of Pseudomonas putida indole acetic acid in development of the host plant root system. Appl. Environ. Microbiol. 2002, 68, 3795–3801. [Google Scholar] [CrossRef]
- Rajeela, T.; Gupta, A.; Gopal, M.; Hegde, V.; Thomas, G. Evaluation of combinatorial capacity of coconut and cocoa plant growth promoting Rhizobacteria (PGPR) with biocontrol agent Trichoderma harzianum. Curr. Investig. Agric. Curr. Res. 2018, 3, 404–409. [Google Scholar]
- Edwards, U.; Rogall, T.; Blöcker, H.; Emde, M.; Böttger, E.C. Isolation and direct complete nucleotide determination of entire genes. Characterization of a gene coding for 16S ribosomal RNA. Nucleic Acids Res. 1989, 17, 7843–7853. [Google Scholar] [CrossRef]
- White, T.J.; Bruns, T.; Lee, S.J.W.T.; Taylor, J.L. Amplification and direct sequencing of fungal ribosomal RNA genes for phylogenetics. PCR Protoc. A Guide Methods Appl. 1990, 18, 315–322. [Google Scholar]
- Kumar, S.; Stecher, G.; Li, M.; Knyaz, C.; Tamura, K. MEGA X: Molecular evolutionary genetics analysis across computing platforms. Mol. Biol. Evol. 2018, 35, 1547–1549. [Google Scholar] [CrossRef] [PubMed]
- Tamura, K.; Nei, M. Estimation of the number of nucleotide substitutions in the control region of mitochondrial DNA in humans and chimpanzees. Mol. Biol. Evol. 1993, 10, 512–526. [Google Scholar] [PubMed]
- Kimura, M. A simple method for estimating evolutionary rates of base substitutions through comparative studies of nucleotide sequences. J. Mol. Evol. 1980, 16, 111–120. [Google Scholar] [CrossRef]
- Irulappan, V.; Mali, K.V.; Patil, B.S.; Manjunatha, H.; Muhammad, S.; Senthil-Kumar, M. A sick plot–based protocol for dry root rot disease assessment in field-grown chickpea plants. Appl. Plant Sci. 2021, 9, e11445. [Google Scholar] [CrossRef]
- Islam, M.A.; Nain, Z.; Alam, M.K.; Banu, N.A.; Islam, M.R. In vitro study of biocontrol potential of rhizospheric Pseudomonas aeruginosa against Fusarium oxysporum f. sp. cucumerinum. Egypt. J. Biol. Pest Control. 2018, 28, 90. [Google Scholar] [CrossRef]
- Dewanto, V.; Wu, X.; Adom, K.K.; Liu, R.H. Thermal processing enhances the nutritional value of tomatoes by increasing total antioxidant activity. J. Agric. Food Chem. 2002, 50, 3010–3014. [Google Scholar] [CrossRef]
- Zou, Y.; Lu, Y.; Wei, D. Antioxidant activity of a flavonoid-rich extract of Hypericum perforatum L. in vitro. J. Agric. Food Chem. 2004, 52, 5032–5039. [Google Scholar] [CrossRef]
- Shannon, L.M.; Key, E.; Law, J.Y. Peroxidase isozymes from horse radish roots: Isolation and physical properties. J. Biol. Chem. 1966, 241, 2166–2172. [Google Scholar] [CrossRef]
- Jockusch, H. Induction of defence responses against Erwinia soft rot by an endogenous pectatelyase in potatoes. Physiol. Mol. Plant Pathol. 2002, 60, 91–100. [Google Scholar]
- Mahatma, M.K.; Thawait, L.K.; Jadon, K.S.; Thirumalaisamy, P.P.; Bishi, S.K.; Jadav, J.K.; Khatediya, N.; Golakiya, B.A. Metabolic profiles of groundnut (Arachis hypogaea L.) genotypes differing in Sclerotium rolfsii reaction. Eur. J. Plant Pathol. 2018, 151, 463–474. [Google Scholar] [CrossRef]
- Mahatma, M.K.; Thawait, L.K.; Jadon, K.S.; Rathod, K.J.; Sodha, K.H.; Bishi, S.K.; Thirumalaisamy, P.P.; Golakiya, B.A. Distinguish metabolic profiles and defense enzymes in Alternaria leaf blight resistant and susceptible genotypes of groundnut. Physiol. Mol. Biol. Plants 2019, 25, 1395–1405. [Google Scholar] [CrossRef] [PubMed]
- Nadarajah, K.; Abdul Rahman, N.S.N. Plant–microbe interaction: Aboveground to belowground, from the good to the bad. Int. J. Mol. Sci. 2021, 22, 10388. [Google Scholar] [CrossRef] [PubMed]
- Kumari, A.; Kumar, R.; Kumar, H. Efficacy of fungicides and Trichoderma viride against Fusarium oxysporum f. sp. cubense in vitro. Bioscan 2014, 9, 1355–1358. [Google Scholar]
- Chiranjeevi, N.; Kumar, M.R.; Padmodaya, B.; Venkateswarlu, N.C.; Sudhakar, P.; Devi, R.S.J.; Sri, P.A. Studies on extraction, evaluation of crude metabolite extract from endophytic Bacillus subtillis and its mechanistic effect on chickpea dry root rot causing pathogen Rhizoctonia bataticola (Taub.) Butler. Pharma Innov. 2021, 10, 898–905. [Google Scholar]
- Rao, A.S.; Nair, A.; Nivetha, K.; More, V.S.; Anantharaju, K.S.; More, S.S. Molecular adaptations in proteins and enzymes produced by extremophilic microorganisms. In Extremozymes and Their Industrial Applications; Arora, N.K., Agnihotri, S., Mishra, J., Eds.; Academic Press: Cambridge, MA, USA, 2022; pp. 205–230. [Google Scholar]
- Paul, D.; Nair, S. Stress adaptations in a plant growth promoting rhizobacterium (PGPR) with increasing salinity in the coastal agricultural soils. J. Basic Microbiol. 2008, 48, 378–384. [Google Scholar] [CrossRef]
- Oleńska, E.; Małek, W.; Wójcik, M.; Swiecicka, I.; Thijs, S.; Vangronsveld, J. Beneficial features of plant growth-promoting rhizobacteria for improving plant growth and health in challenging conditions: A methodical review. Sci. Total Environ. 2020, 743, 140682. [Google Scholar] [CrossRef]
- Yue, Z.; Chen, Y.; Hao, Y.; Wang, C.; Zhang, Z.; Chen, C.; Liu, H.; Liu, Y.; Li, L.; Sun, Z. Bacillus sp. WR12 alleviates iron deficiency in wheat via enhancing siderophore-and phenol-mediated iron acquisition in roots. Plant Soil 2022, 471, 247–260. [Google Scholar] [CrossRef]
- Singh, M. Purification, Homology Modeling and Structural Analysis of Pathogenesis Related Class I Chitinase from Seed Coat of Glycine max [L.]. Master’s Thesis, Institute of Agricultural Sciences, Banaras Hindu University, Varanasi, Uttar Pradesh, India, 2017. [Google Scholar]
- Gopalakrishnan, S.; Srinivas, V.; Prakash, B.; Sathya, A.; Vijayabharathi, R. Plant growth-promoting traits of Pseudomonas geniculata isolated from chickpea nodules. 3 Biotech 2015, 5, 653–661. [Google Scholar] [CrossRef]
- Kaur, M.; Karnwal, A. Screening of endophytic Bacteria from stress-tolerating plants for abiotic stress tolerance and plant growth-promoting properties: Identification of potential strains for bioremediation and crop enhancement. J. Agric. Food Res. 2023, 14, 100723. [Google Scholar] [CrossRef]
- Raheem, A.; Shaposhnikov, A.; Belimov, A.A.; Dodd, I.C.; Ali, B. Auxin production by rhizobacteria was associated with improved yield of wheat (Triticum aestivum L.) under drought stress. Arch. Agron. Soil Sci. 2018, 64, 574–587. [Google Scholar] [CrossRef]
- Niu, B.; Wang, W.; Yuan, Z.; Sederoff, R.R.; Sederoff, H.; Chiang, V.L.; Borriss, R. Microbial interactions within multiple-strain biological control agents impact soil-borne plant disease. Front. Microbiol. 2020, 11, 585404. [Google Scholar] [CrossRef] [PubMed]
- Syed, S.; Tollamadugu, N.P.; Lian, B. Aspergillus and Fusarium control in the early stages of Arachis hypogaea (groundnut crop) by plant growth-promoting rhizobacteria (PGPR) consortium. Microbiol. Res. 2020, 240, 126562. [Google Scholar] [CrossRef] [PubMed]
- Asad, S.A. Mechanisms of action and biocontrol potential of Trichoderma against fungal plant diseases—A review. Ecol. Complex. 2022, 49, 100978. [Google Scholar] [CrossRef]
- Mukherjee, P.K.; Mendoza-Mendoza, A.; Zeilinger, S.; Horwitz, B.A. Mycoparasitism as a mechanism of Trichoderma-mediated suppression of plant diseases. Fungal Biol. Rev. 2022, 39, 15–33. [Google Scholar] [CrossRef]
- Dimkić, I.; Janakiev, T.; Petrović, M.; Degrassi, G.; Fira, D. Plant-associated Bacillus and Pseudomonas antimicrobial activities in plant disease suppression via biological control mechanisms—A review. Physiol. Mol. Plant Pathol. 2022, 117, 101754. [Google Scholar] [CrossRef]
- Panpatte, D.G.; Jhala, Y.K.; Shelat, H.N.; Vyas, R.V. Pseudomonas fluorescens: A Promising Biocontrol Agent and PGPR for Sustainable Agriculture. In Microbial Inoculants in Sustainable Agricultural Productivity; Singh, D., Singh, H., Prabha, R., Eds.; Springer: New Delhi, India, 2016; pp. 257–270. [Google Scholar] [CrossRef]
- Chakraborty, S.; Islam, T.; Mahapatra, S. Antifungal Compounds of Plant Growth-Promoting Bacillus Species. In Antifungal Metabolites of Rhizobacteria for Sustainable Agriculture; Sayyed, R., Singh, A., Ilyas, N., Eds.; Fungal Biology; Springer: Cham, Switzerland, 2022; pp. 135–155. [Google Scholar] [CrossRef]
- Zeidan, R.; Hassan, Z.U.; Ashfaq, M.Y.; Al-Thani, R.; Jaoua, S. Investigation of heat-resistant antifungal agents from Bacillus amyloliquefaciens and Bacillus subtilis for biocontrol of mycotoxigenic fungi. Environ. Technol. Innov. 2024, 36, 103748. [Google Scholar] [CrossRef]
- Dhawan, A.; Kumar, S.A.T.I.S.H.; Sharma, P.K.; Chugh, R.K. Effect of different fungicides, organic amendments and bio-control agents on dry root rot of cluster bean [Cyamopsis tetragonoloba (L.) Taub] caused by Rhizoctonia bataticola (Taub.) butler. Forage Res. 2019, 44, 276–281. [Google Scholar]
- Singh, B.K.; Srivastava, M.; Narain, U. Evaluation of biogents Rhizoctonia bataticola causing chickpea dry root rot. Farm Sci. J. 2003, 12, 48–49. [Google Scholar]
- Waqas, M.; Khan, A.L.; Hamayun, M.; Shahzad, R.; Kim, Y.H.; Choi, K.S.; Lee, I.J. Endophytic infection alleviates biotic stress in sunflower through regulation of defence hormones, antioxidants and functional amino acids. Eur. J. Plant Pathol. 2015, 141, 803–824. [Google Scholar] [CrossRef]
- Pieterse, C.M.; Zamioudis, C.; Berendsen, R.L.; Weller, D.M.; Van Wees, S.C.; Bakker, P.A. Induced systemic resistance by beneficial microbes. Annu. Rev. Phytopathol. 2014, 52, 347–375. [Google Scholar] [CrossRef] [PubMed]
- Haas, D.; Défago, G. Biological control of soil-borne pathogens by fluorescent pseudomonads. Nat. Rev. Microbiol. 2005, 3, 307–319. [Google Scholar] [CrossRef] [PubMed]
- Ryu, C.M.; Farag, M.A.; Hu, C.H.; Reddy, M.S.; Wei, H.X.; Paré, P.W.; Kloepper, J.W. Bacterial volatiles promote growth in Arabidopsis. Proc. Natl. Acad. Sci. USA 2003, 100, 4927–4932. [Google Scholar] [CrossRef] [PubMed]
- Kumar, S.M.; Chowdappa, P.; Krishna, V. Development of seed coating formulation using consortium of Bacillus subtilis OTPB1 and Trichoderma harzianum OTPB3 for plant growth promotion and induction of systemic resistance in field and horticultural crops. Indian Phytopath. 2015, 68, 25–31. [Google Scholar]
- Singh, D.; Jadon, K.S.; Verma, A.; Geat, N.; Sharma, R.; Meena, K.K.; Kakani, R.K. Formulations of synergistic microbial consortia for enhanced systemic resistance against Fusarium wilt in cumin. Int. Microbiol. 2024, 1–27. [Google Scholar] [CrossRef]
- Mishra, M.; Singh, S.K.; Kumar, A. Microbial consortia: Approaches in crop production and yield enhancement. In Microbiome Stimulants for Crops; White, J., Kumar, A., Droby, S., Eds.; Woodhead Publishing: Sawston, UK, 2021; pp. 293–303. [Google Scholar]
- Gautam, S.S.; Kanchan, K.; Satsangi, G.P. Effect of Trichoderma species on germination and growth of Mungbean (Vigna radiata L.) and its antagonistic effect against fungal pathogens. Int. J. Adv. Res. 2015, 3, 153. [Google Scholar]
- Srivastava, R.; Khalid, A.; Singh, U.S.; Sharma, A.K. Evaluation of arbuscular mycorrhizal fungus, Pseudomonas fluorescens and Trichoderma harzianum formulation against Fusarium oxysporum f. sp. lycopersici for the manage-ment of tomato wilt. Biol. Control 2010, 53, 24–31. [Google Scholar] [CrossRef]
- Vyas, P.; Gulati, A. Organic acid production in vitro and plant growth promotion in maize under controlled environment by phosphate-solubilizing fluorescent Pseudomonas. BMC Microbiol. 2009, 9, 174. [Google Scholar] [CrossRef]
- Kaur, A.; Devi, S.R.; Vyas, P. Stress-tolerant antagonistic plant growth-promoting rhizobacteria from Zea mays. J. Plant Prot. Res. 2018, 58, 115–128. [Google Scholar] [CrossRef]
- Choudhary, A.; Ashraf, S. Utilizing the combined antifungal potential of Trichoderma spp. and organic amendments against dry root rot of mungbean. Egypt. J. Biol. Pest Control 2019, 29, 83. [Google Scholar] [CrossRef]
- Vetrivelkalai, P.; Sivakumar, M.; Jonathan, E.I. Biocontrol potential of endophytic bacteria on Meloidogyne incognita and its effect on plant growth in Bhendi. J. Biopestic. 2010, 3, 452–457. [Google Scholar] [CrossRef]

| Isolates | Siderophore | HCN | Ammonia | Chitinase | Beta-1,3, Glucanase | Cellulase | Chitosanase | IAA | P Solubilization | Zn Solubilization |
|---|---|---|---|---|---|---|---|---|---|---|
| 1F | ++ | +++ | ++ | +++ | ++ | ++ | ++ | ++ | + | + |
| 5F | +++ | +++ | ++ | +++ | +++ | +++ | ++ | ++ | + | + |
| 37F | ++ | ++ | ++ | ++ | +++ | ++ | +++ | ++ | + | + |
| 42F | +++ | ++ | +++ | +++ | ++ | ++ | ++ | ++ | + | + |
| 131B | +++ | ++ | +++ | +++ | +++ | − | + | +++ | ++ | +++ |
| 223B | +++ | ++ | +++ | ++ | ++ | − | +++ | +++ | +++ | +++ |
| 236B | +++ | ++ | +++ | ++ | +++ | − | ++ | +++ | +++ | +++ |
| 242B | ++ | + | ++ | + | ++ | − | + | + | ++ | ++ |
| 325B | + | + | + | + | + | − | + | ++ | ++ | ++ |
| 390B | ++ | + | ++ | ++ | + | − | ++ | ++ | + | + |
| Treatments | PDI (Percent Disease Index) | Percent Disease Control over the Infected Control |
|---|---|---|
| T1: No pathogen + No biocontrol agent (mock control) | 11.0 ± 2.7 f | - |
| T2: Only Rhizoctonia bataticola (infected control) | 94.44.0 ± 8.7 a | - |
| T3: Trichoderma afroharzianum 5F + challenged with R. bataticola | 55.55 ± 6.9 c | 41.2 |
| T4: Pseudomonas fluorescens 131B + challenged with R. bataticola | 61.78 ± 5.7 bc | 34.6 |
| T5: Bacillus licheniformis 223B + challenged with R. bataticola | 66.67 ± 4.0 b | 29.4 |
| T6: Bacillus subtilis 236B + challenged with R. bataticola | 61.78 ± 5.7 bc | 34.6 |
| T7: 131B + 223B + 236B + challenged with R. bataticola | 38.88 ± 6.0 d | 58.8 |
| T8: 5F + 131B + 223B + 236B + challenged with R. bataticola | 22.2 ± 2.0 e | 76.5 |
| Treatments | Total Phenol (mg Gallic Acid g−1 F.W.) | Flavonoids (mg Quercitin g−1 F.W.) | Peroxidase (U min−1 g−1 F.W.) | Polyphenol Oxidase (U min−1 g−1 F.W.) | Phenylalanine Ammonia Lyase (U h−1 g−1 F.W.) | Tyrosine Ammonia Lyase (U h−1 g−1 F.W.) |
|---|---|---|---|---|---|---|
| T1: No pathogen + No biocontrol agent (mock control) | 2.8 ± 0.2 d | 15.2 ± 2.1 d | 1.9 ± 0.2 c | 9.2 ± 1.3 c | 3.2 ± 0.6 e | 18.1 ± 2.2 e |
| T2: Only Rhizoctonia bataticola (infected control) | 3.8 ± 0.7 cd | 21.3 ± 3.2 d | 2.6 ± 0.3 c | 13.2 ± 1.0 c | 5.2 ± 0.2 d | 24.4 ± 2.1 de |
| T3: Trichoderma afroharzianum 5F + challenged with R. bataticola | 5.3 ± 0.6 b | 35.8 ± 3.4 c | 5.2 ± 0.8 b | 20.1 ± 2.1 b | 7.1 ± 1.0 bc | 39.5 ± 5.0 bc |
| T4: Pseudomonas fluorescens 131B + challenged with R. bataticola | 4.9 ± 0.5 bc | 30.2 ± 4.0 c | 4.8 ± 0.9 b | 21.1 ± 2.0 b | 6.4 ± 0.9 bcd | 31.2 ± 4.0 cd |
| T5: Bacillus licheniformis 223B + challenged with R. bataticola | 4.7 ± 0.7 bc | 32.0 ± 4.0 c | 4.9 ± 0.6 b | 21.4 ± 2.1 b | 6.2 ± 0.4 cd | 33.4 ± 5.0 c |
| T6: Bacillus subtilis 236B + challenged with R. bataticola | 4.1 ± 0.8 bcd | 30.3 ± 4.4 c | 5.0 ± 0.8 b | 19.8 ± 1.7 b | 6.1 ± 0.9 cd | 34.1 ± 4.1 c |
| T7: 131B + 223B + 236B + challenged with R. bataticola | 7.2 ± 1.3 a | 43.4 ± 4.1 b | 6.1 ± 1.2 b | 26.7 ± 1.3 a | 7.9 ± 1.3 ab | 45.0 ± 8.1 b |
| T8: 5F + 131B + 223B + 236B + challenged with R. bataticola | 7.3 ± 1.1 a | 51.3 ± 4.4 a | 7.5 ± 1.0 a | 28.5 ± 5.1 a | 8.9 ± 1.5 a | 56.0 ± 7.1 a |
| Treatments | Plant Height (cm) at 70 Days After Sowing (DAS) | Fresh Weight (g) (70 DAS) | Dry Weight (g) (70 DAS) | Number of Pods Plant−1 | Yield (g Pot−1) |
|---|---|---|---|---|---|
| T1: No pathogen + No biocontrol agent (mock control) | 63.5 ± 4.0 c | 63.0 ± 4.5 b | 16.5 ± 2.6 bc | 19.0 ± 2.0 a | 32.0 ± 1.5 ab |
| T2: Only Rhizoctonia bataticola (infected control) | 51.25 ± 4.0 d | 35.0 ± 4.0 c | 9.0 ± 1.7 e | 3.0 ± 1.0 e | 1.3 ± 0.4 e |
| T3: Trichoderma afroharzianum 5F + challenged with R. bataticola | 63.0 ± 7.0 c | 62.3 ± 5.1 b | 16.5 ± 1.3 bc | 15.0 ± 2.0 bc | 24.8 ± 3.2 cd |
| T4: Pseudomonas fluorescens 131B + challenged with R. bataticola | 69.0 ± 4.5 abc | 60.0 ± 4.9 b | 15.3 ± 1.0 bcd | 14.0 ± 1.0 bcd | 21.0 ± 1.7 d |
| T5: Bacillus licheniformis 223B + challenged with R. bataticola | 67.0 ± 4.1 bc | 59.8 ± 4.8 b | 14.9 ± 1.3 cd | 13.0 ± 1.0 cd | 20.1 ± 2.2 d |
| T6: Bacillus subtilis 236B + challenged with R. bataticola | 67.3 ± 4.9 bc | 56.3 ± 4.1 b | 13.3 ± 1.4 d | 12.0 ± 2.0 d | 19.2 ± 2.5 d |
| T7: 131B + 223B + 236B + challenged with R. bataticola | 73.0 ± 3.6 ab | 72.8 ± 5.9 a | 18.0 ± 2.2 ab | 16.0 ± 1.0 b | 27.4 ± 5.8 bc |
| T8: 5F + 131B + 223B + 236B + challenged with R. bataticola | 77.0 ± 5.4 a | 75.8 ± 4.3 a | 19.5 ± 1.3 a | 21.0 ± 1.0 a | 36.1 ± 6.2 a |
Disclaimer/Publisher’s Note: The statements, opinions and data contained in all publications are solely those of the individual author(s) and contributor(s) and not of MDPI and/or the editor(s). MDPI and/or the editor(s) disclaim responsibility for any injury to people or property resulting from any ideas, methods, instructions or products referred to in the content. |
© 2024 by the authors. Licensee MDPI, Basel, Switzerland. This article is an open access article distributed under the terms and conditions of the Creative Commons Attribution (CC BY) license (https://creativecommons.org/licenses/by/4.0/).
Share and Cite
Singh, D.; Geat, N.; Jadon, K.S.; Verma, A.; Sharma, R.; Rajput, L.S.; Mahla, H.R.; Kakani, R.K. Isolation and Characterization of Biocontrol Microbes for Development of Effective Microbial Consortia for Managing Rhizoctonia bataticola Root Rot of Cluster Bean Under Hot Arid Climatic Conditions. Microorganisms 2024, 12, 2331. https://doi.org/10.3390/microorganisms12112331
Singh D, Geat N, Jadon KS, Verma A, Sharma R, Rajput LS, Mahla HR, Kakani RK. Isolation and Characterization of Biocontrol Microbes for Development of Effective Microbial Consortia for Managing Rhizoctonia bataticola Root Rot of Cluster Bean Under Hot Arid Climatic Conditions. Microorganisms. 2024; 12(11):2331. https://doi.org/10.3390/microorganisms12112331
Chicago/Turabian StyleSingh, Devendra, Neelam Geat, Kuldeep Singh Jadon, Aman Verma, Rajneesh Sharma, Laxman Singh Rajput, Hans Raj Mahla, and Rajesh Kumar Kakani. 2024. "Isolation and Characterization of Biocontrol Microbes for Development of Effective Microbial Consortia for Managing Rhizoctonia bataticola Root Rot of Cluster Bean Under Hot Arid Climatic Conditions" Microorganisms 12, no. 11: 2331. https://doi.org/10.3390/microorganisms12112331
APA StyleSingh, D., Geat, N., Jadon, K. S., Verma, A., Sharma, R., Rajput, L. S., Mahla, H. R., & Kakani, R. K. (2024). Isolation and Characterization of Biocontrol Microbes for Development of Effective Microbial Consortia for Managing Rhizoctonia bataticola Root Rot of Cluster Bean Under Hot Arid Climatic Conditions. Microorganisms, 12(11), 2331. https://doi.org/10.3390/microorganisms12112331

